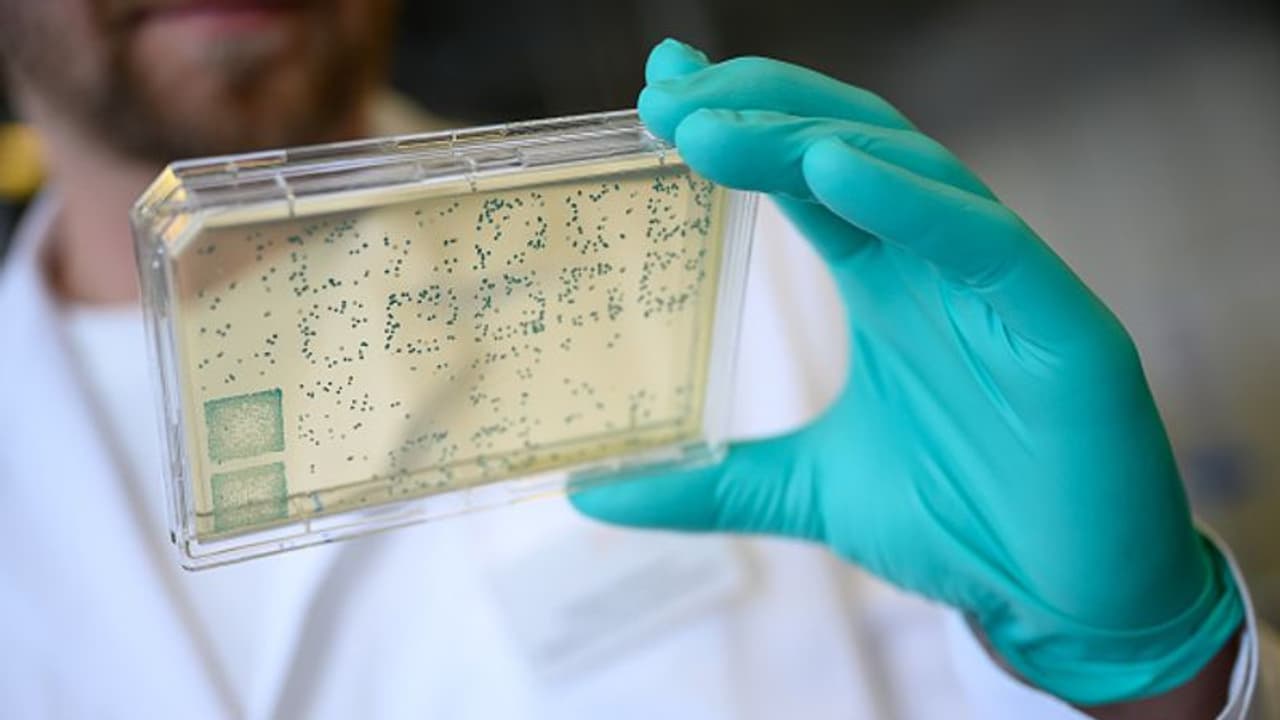
a man is looking at a carrier with bacteria from which DNA and subsequently RNA is obtained a man is looking at a carrier with bacteria from which DNA and subsequently RNA is obtained

চিনের গন্ডি পার করে তা ভারত সহ বিভিন্ন দেশে ছড়িয়েছে এই রোগ। শ্বাসকষ্ট এবং শ্বাসযন্ত্রের সমস্যাই এই রোগের মূল উপসর্গ।
করোনার পর চিন্তা বাড়াচ্ছে চিনা নিউমোনিয়া। চিনের গন্ডি পার করে তা ভারত সহ বিভিন্ন দেশে ছড়িয়েছে এই রোগ। শ্বাসকষ্ট এবং শ্বাসযন্ত্রের সমস্যাই এই রোগের মূল উপসর্গ।
এদিকে দিল্লির অল ইন্ডিয়া ইনস্টিটিউট অফ মেডিক্যাল সায়েন্স সদ্য প্রকাশ্যে এনেছে এক বিশেষ রিপোর্ট। যা দেখে চমক পেয়েছেন সকলে। তাঁরা একটি বিশেষ গবেষণা চালাচ্ছিলেন। এই গবেষণা করতে গিয়ে হাসপাতাল থেকে সংগৃহীত নমুনার মধ্যে সাতটি মাইক্রোপ্লাজমা নিউমোনিয়ার উপস্থিতি সনাক্ত করেছেন।
জানা গিয়েছে, ১ এপ্রিল থেকে ৩০ সেপ্টেম্বর এই ছয় মাস পরীক্ষা করেন তাঁরা। যা পিসিআর পরীক্ষার মাধ্যমে সনাক্ত করা সম্ভব। দিল্লির অল ইন্ডিয়া ইনস্টিটিউট অফ মেডিক্যাল সায়েন্স মাইক্রোবায়োলজি বিভাগের প্রাক্তন প্রধান ডাঃ রমা চৌধুরী জানিয়েছেন, এই ব্যাকটেরিয়া দ্বারা সৃষ্টি নিউমোনিয়া সাধারণত হালকা হয়। এটিকে Walking Pneumonia বলা হয়। কিন্তু, অনেক সময় ব্যতিক্রম হতে পারে বলে জানা গিয়েছে।
কোভিড ১৯-র স্মৃতি সকলের ফের মনে পড়েছে। কারণ, সে সময়ের মতো ফের চিনে আক্রান্তের সংখ্যআ বাড়ছে। অনেকেই নিউমোনিয়ায় আক্রান্ত হয়ে হাসপাতালে ভর্তি হচ্ছেন। এই নিউমোনিয়ার ভাইরাসটি দ্রুত ইউকে, ইউএস, ইজরায়েল, ভারতের মতো দেশে ছড়িয়ে পড়ছে বলে জানা গিয়েছে।
তবে, এই চিনা নিউমোনিয়া প্রসঙ্গে এখনও পর্যন্ত কোনও তথ্য দেয়নি চিন। এটি সার্স-কোভ-২ আরএসভি, ইনফ্লুয়েঞ্জা ও মাইক্রোপ্লাজমা নিউমোনিয়ার মতো ব্যাকটেরিয়া ঘটিত সংক্রমণ বলে মনে করছে বিশ্ব স্বাস্থ্য সংস্থা। গত তিন বছরে ধরে সামাজিক দূরত্ব মেনে চলা, মাস্ক ব্যবহারের কারণে জীবাণুর সংক্রমণ কম হচ্ছিল তবে ফের তা বেড়েছে। এখন কোভিড বিধি প্রত্যাহার করায় নতুন রূপে ফিরে আসছে মাইকোপ্লাজমা নিউমোনিয়া। এমনই তথ্য এসেছে সামনে। যা চিন্তার ভাঁজ ফেলেছে সকলের কপালে।
আরও খবরের আপডেট পেতে চোখ রাখুন আমাদের হোয়াটসঅ্যাপ চ্যানেলে, ক্লিক করুন এখানে।
আরও পড়ুন
পাপুয়া নিউ গিনিতে আগ্নেয়গিরির অগ্ন্যুৎপাত: ৮ কোটি টাকা আর্থিক সাহায্য ভারতের
Viral Video: দোকানের মধ্যে ঘুরে বেড়াচ্ছে অজগর, ভিডিও দেখে শিউরে উঠেছেন নেটিজেনরা